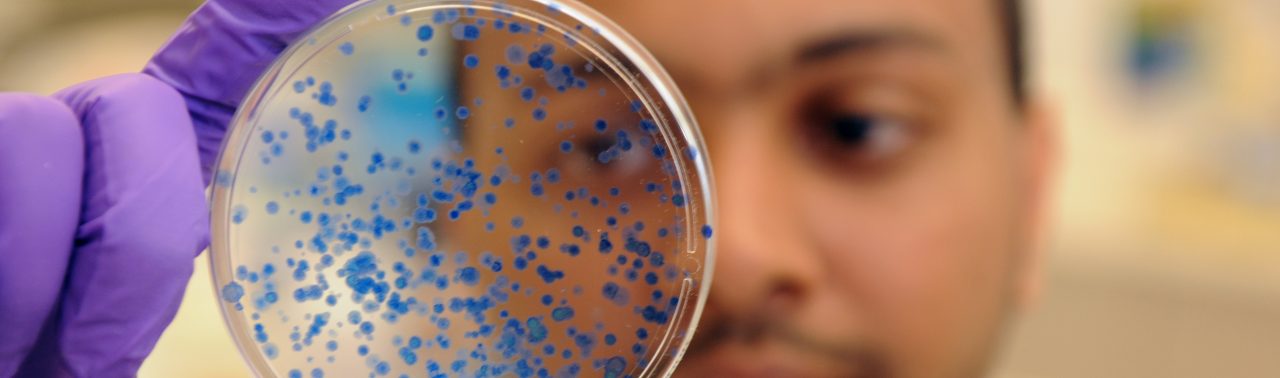

Empowered to make a difference
Dalhousie offers more than 130 master’s and PhD programs. Whether you choose a research-based degree that accelerates knowledge or a professional program to build your job-ready skills, you’ll be set on a path to make a difference in your life, career and world.
Research with impact
From agriculture to engineering, food security to sociology, clean tech to community health, Dalhousie graduate students are advancing knowledge and having an impact.

Students are building the next generation of lithium batteries in a partnership with Tesla.

Students are riding Dalhousie’s wave as a global centre for ocean research.

Students are expanding their understanding of the world and addressing global challenges with the arts and social sciences.

Students are advancing medical and health research in areas like genomics, brain health, bioinformatics and vaccinology.

Students are leading the charge into the digital frontier by studying big data analytics, artificial intelligence and machine learning.
Drive your career
Dalhousie’s professional master’s programs equip students to take charge of their careers with experiential learning and industry experience, making Dal a launch pad for career success — no matter what undergrad degree you start with.

Computer Science and Engineering programs focused on technical skills in high-growth areas such as digital innovation and data management.

Management programs that launch careers in business and public administration with impactful work experiences.